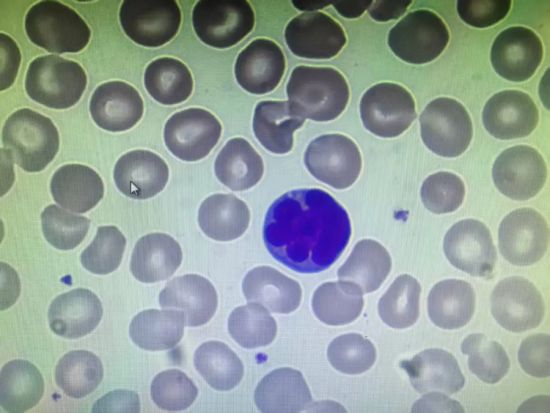
������ɫ���Ϊ����Tõ�廨��һ��������ϸ��

提到白血病,大家普遍认为它不会传染,但血液科学科带头人付海英教授提醒:大多数白血病确实无传染性,却有一类特殊的成人T细胞白血病/淋巴瘤,与可传播的人类T细胞白血病病毒1型(HTLV-I)密切相关。这种“病毒诱发的血液肿瘤”需引起所有人的高度警惕。在防治策略上,融合现代医学的精准筛查与中医药“治未病”及“扶正祛邪”的智慧,进行中西医协同的全程管理,是尤为关键的方向。
近期,在血液科病房中,一位年轻患者确诊成人T细胞白血病/淋巴瘤,检查显示HTLV-I阳性,后续家庭筛查又发现多位亲属均感染该病毒。家属满心疑惑:“白血病不是不传染吗?为什么家人都查出了这个病毒?”
付海英教授表示,这一问题的核心答案很明确:白血病本身不会在人与人之间直接传播,但诱发这种特殊白血病的HTLV-I病毒可以通过特定途径传播,且感染者中约3-5%会发展为成人T细胞白血病/淋巴瘤。预防病毒感染,就是预防这种血液肿瘤的最前端关口。从中医理论看,病毒属于“外邪”范畴,其能否致病及致病后的转归,与人体的“正气”(即免疫力)强弱密切相关。因此,防治并重,固护正气,具有深远意义。
一个被忽视的真相:
病毒,如何成为血液肿瘤的“启动键”?
作为一种高度侵袭性的淋巴系统恶性肿瘤,成人T细胞白血病/淋巴瘤的发生犹如一场“蝴蝶效应”:HTLV-I病毒入侵人体后,凭借独特的“嗜T细胞”特性,将基因整合到人体T淋巴细胞的DNA中,经过长期潜伏,引发人体免疫失衡,最终触发细胞恶变,整个过程可能长达20-30年。中医将这一漫长过程理解为“邪气”伏藏于体内,暗耗人体精血与正气,导致机体阴阳失调、脏腑功能紊乱,最终导致血液肿瘤内生。
传播途径:了解它,才能阻断它
想要阻断病毒传播,首先要明确其传播途径:
A
母婴传播(最主要途径):
主要通过母乳喂养传播,感染率可达20-25%,宫内和产道感染相对较少。预防关键是对感染母亲做产前筛查,由医生指导科学喂养方式。
性传播:
精液和阴道分泌物中存在病毒,无保护性行为是成人主要传播途径,需做好安全性行为防护,高危人群定期筛查。
C
血液传播:
可通过输入未筛查血液制品、静脉吸毒者共用注射器传播。我国已对所有献血者开展HTLV-I/II抗体筛查,基本阻断了输血传播渠道。
识别高危人群:这些人需要特别关注
结合临床诊疗经验,付海英教授强调,以下几类高危人群需及时做HTLV-I抗体筛查:
1.来自日本西南部、加勒比海地区;我国福建、广东、台湾等地的HTLV病毒流行区域与确诊患者有密切接触者;
2.HTLV-I感染者的一级亲属、有不安全性行为者、静脉药瘾者;
3.出现不明原因淋巴结/肝脾肿大、持续性皮疹、高钙血症、反复机会性感染的人群。
从感染到发病:一个长达数十年的“潜伏期”
HTLV-I感染后的自然病程差异显著,95%以上的感染者为终身无症状的携带状态,却仍具有传染性,常规体检难以发现,需定期监测病毒载量和免疫状态;少数感染者会进入前驱状态,出现脊髓病、葡萄膜炎、慢性皮炎等症状;仅有3-5%的感染者会在潜伏期后发展为成人T细胞白血病/淋巴瘤,分为急性型、淋巴瘤型、慢性型和隐袭型,其中急性型侵袭性最强。中医认为,无症状携带状态相当于“正气存内,邪不可干”或“正邪相持”的阶段,是进行干预、扶助正气、防止疾病传变(即向血液肿瘤发展)的最佳时机。
中西医协同,构筑三级防线
对此,付海英教授带领的血液科团队给出了明确的筛查与预防策略,核心是建立中西医优势互补的三级防线:
A
第一道防线:防止病毒感染
(未病先防)
现代医学策略:高流行区推广产前筛查,感染母亲避免母乳喂养,做好安全性行为教育,持续加强血液制品筛查。
中医协同策略:积极践行“治未病”思想。通过中医体质辨识,了解自身体质偏颇(如气虚、阴虚、湿热等),运用饮食调理、情志疏导、规律作息、传统养生功法(如太极拳、八段锦)等方法,增强整体正气,改善内环境,提升抗御“外邪”(病毒)入侵的能力。
第二道防线:早期发现与管理
(既病防变)
现代医学策略:高危人群主动做血清学初筛,阳性者通过核酸检测确诊。感染者每6-12个月定期随访监测,及时治疗并发症。
中医协同策略:对于HTLV-I无症状携带者,在定期监测的同时,可寻求中医辨证论治。中医师会根据个体情况(如乏力、口干、失眠、舌脉象等),采用益气养阴、清热解毒、疏肝健脾、活血化瘀等治法,配制中药汤剂或膏方,旨在调节免疫平衡,扶助正气,抑制邪气,力求扭转“正邪相持”的状态,延缓或阻断其向疾病进展,实现“既病防变”。
C
第三道防线:规范治疗疾病
(愈后防复)
现代医学策略:一旦发展为成人T细胞白血病/淋巴瘤,尽早开展化疗、靶向治疗、造血干细胞移植等规范治疗,由多学科团队进行综合管理。
中医协同策略:在规范现代医学治疗全过程中,中医药可发挥重要的协同减毒、增效固本作用。
治疗期(减毒):通过健脾和胃、益气生血、滋补肝肾的中药,可有效缓解放化疗引起的骨髓抑制、消化道反应、肝功能损伤等,帮助患者顺利完成治疗。
恢复期(防复):治疗结束后,运用中医药巩固疗效,重建机体免疫平衡。通过辨证调理,清除余毒,修复受损脏腑功能,增强体质,减少感染等并发症,降低复发风险,提高长期生存质量。
一个家庭的启示:中西医结合如何改变命运
文章开头提到的家庭,在进行了全面的HTLV-I筛查与中西医结合管理后:患者确诊后接受了付海英教授团队制定的化疗联合靶向治疗方案,并全程配合中医药辅助治疗,旨在减毒增效、巩固疗效,病情现已稳定;其HTLV-I阳性的父母开始定期监测,同时接受中医调理以增强正气、改善体质;未感染的亲属掌握了预防知识,并开始注重中医养生,规避了传播风险。
家属感慨:“若早知道可以这样中西医结合地管理,早筛查、早调理,就能更科学、更全面地守护家人健康。”
这也正是科普的意义所在:成人T细胞白血病/淋巴瘤的侵袭性虽强,但它有着清晰的病毒病因,这让预防成为可能。HTLV-I的传播可防、可阻断,由它引发的恶性疾病也能通过早筛查、早干预,并结合中西医之长进行全程管理来有效应对。
付海英教授最后提醒:一次简单的HTLV-I抗体筛查,可能改变整个家庭的健康轨迹。对于高危人群而言,主动筛查就是守护健康的最佳开端;而了解这种特殊疾病,认识它的病毒元凶,并充分理解中西医在预防、治疗、康复各环节的协同价值,就是我们抵御风险、护航健康的最坚实一步。毕竟在血液肿瘤的防治中,“预防为主、防治结合、中西医并重”的理念,永远闪烁着智慧的光芒。